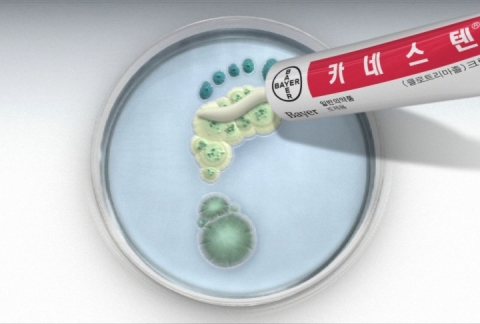

- 좀처럼 낫지 않는 무좀 고민, 여러 종류의 원인균에 대한 꾸준한 치료만이 지름길
- 무좀 발 시각화로 소비자들의 눈길 끌며 광범위 항진균제 사용의 중요성 설명…무좀 치료제 시장에서 입지를 다져나갈 터
바이엘 헬스케어는 무좀의 원인균이 다양하다는 점을 시각화한 이번 광고를 통해 소비자들에게 무좀 치료를 위한 올바른 방법을 소개하고, 무좀 치료제 시장에서 입지를더욱 넓히겠다는 전략이다.
카네스텐® 크림은 샬레 안에 피부사상균, 칸디다균, 기타 진균 등의 곰팡이들이 순차적으로 피어나 발 모양을 형성하는 것을 주요 광고 이미지로 사용, 무좀을 유발하는 원인균이 다양하다는 점을 시각적으로 설명한다.
또한 “자꾸만 재발하는 무좀은 다양한 원인균 때문”이라는 내레이션을 통해 무좀 치료를 위해서는 다양한 원인균에 대한 치료가 중요하다는 메시지와 함께 카네스텐® 크림의 광범위 항진균 치료 효과를 내세워 다른 무좀 치료제들과의 차별을 뒀다.
바이엘 헬스케어의 카네스텐 마케팅 담당 김미리PM은 “무좀은 피부사상균, 칸디다균, 기타 진균 등 다양한 원인균에 의해 발생할 뿐 아니라 세균에 의한 2차 감염까지 오게 될 경우, 피부질환은 물론 가려움과 심한 악취가 나기 십상”이라며“대부분의 무좀 환자들이 증상을 인지하지 못하는 경우보다 원인과 치료 방법 등을 정확히 몰라 재발하는 경우가 많은 만큼, 무좀균으로 뒤덮인 발을 시각적으로 보여주며 소비자들이 자연스럽게 무좀에 대한 정보를 습득할 수 있도록 하는데 중점을 뒀다”고 말했다.
바이엘 헬스케어의 카네스텐® 크림은 전세계에서 가장 많이 판매되는 항진균제인 카네스텐® 브랜드 중 하나로, 무좀의 원인이 되는 피부사상균, 칸디다균, 기타 진균 등을 직접 살균시키는 광범위 항진균 치료제이다.
클로트리마졸을 주 성분으로 하여 다양한 무좀 원인균에 대한 치료뿐만 아니라 손상된 피부의 재생 효과까지 제공하며 안전한 완치를 돕는 카네스텐® 크림은 일반의약품으로 의사 처방전 없이 약국에서만 구입할 수 있다. 공식 판매 가격은 8,500원(20g)이다.
바이엘코리아 개요
바이엘 코리아㈜는 1955년 한국 진출 이래 서울과 평택, 대전, 안성, 반월, 김해 등에 사무실과 연구소, 생산시설을 갖추고 약 천 여명의 직원이 근무하는 회사로 꾸준히 성장해 왔다. 현재 한국 내 바이엘 그룹은 아스피린을 통하여 잘 알려져 있는 바이엘 헬스케어(Bayer Healthcare), 첨단 화학 소재 및 플라스틱시트 제조 및 수출을 담당하는 바이엘 머티리얼사이언스(Bayer MaterialScience), 작물 보호를 포함한 환경과학 및 생명과학 분야에서 세계적인 명성을 얻고 있는 바이엘 크롭사이언스㈜(Bayer CropScience)로 구성되어 있다.
웹사이트: http://www.bayer.co.kr
연락처
홍보대행 PRGATE
한지현 과장
02-792-2633
이메일 보내기